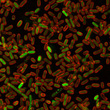

Join us in investigating the importance of interactions between microbes, their hosts and the immune system in human health and disease.
About the Program
As a student in the Immunology & Microbiology Graduate Program at Baylor College of Medicine, you will receive a personalized, inquiry-based education and actively acquire a sophisticated understanding of basic and translational immunology and microbiology problems and state-of-the-art techniques. We also emphasize the development of critical thinking, creativity, and problem-solving skills necessary for diverse scientific careers. Our interdisciplinary faculty members have diverse research interests that span many aspects of basic, translational, and clinical immunology and microbiology. This broad spectrum of topics provides rich opportunities for collaborative and interdisciplinary thesis projects at the cutting-edge of training in these fields.
Diverse Perspectives
Our program draws together faculty members with shared interests in immunology and microbiology to provide a diversity of scientific perspectives.
Where Will Your Ph.D. Take You?
Our graduates have gone on to build successful careers in academia, industry, law, consulting and more. Whatever your vision for your career entails, we will provide the training, resources and support to help you realize your ambition.
Immunology & Microbiology News

Taking a closer look into the tumor microenvironment with nano-radiomics
Research has shown that the tumor microenvironment (TME) can participate in the fight against cancer, but also can promote its growth and help the tumor evade the immune response. Assessing the effectiveness of new therapies on the TME is challenging. In a report published in Science Advances, BCM researchers describe a novel, noninvasive method they developed to assess the effect of a cellular immunotherapy treatment specifically directed at the TME.

Mystery Solved, rotavirus VP3 is a unique capping machine
After eluding researchers for more than 30 years, the VP3 protein of rotavirus has finally revealed its unique structure and function to a team led by labs at Baylor College of Medicine. The researchers knew that VP3 was necessary for capping messenger-RNA (mRNA), a process essential for the synthesis of viral proteins and for evading the host’s immune response, but while the structure and function of the other rotavirus proteins had progressively been unveiled, VP3 remained the last unsolved rotavirus mystery.

Genetic signature may identify mothers at risk for preeclampsia
For years, researchers have looked for single gene mutations that could be strongly associated with risk of preeclampsia, but the results have not been encouraging. Previous work suggested that a genetic factor seemed to predispose to preeclampsia, but its identification has been elusive. BCM researchers discovered that a unique combination of variants of these three genes was associated with increased complement activation and preeclampsia.

Connecting interferon, neuroinflammation and synapse loss in Alzheimer’s disease
Inflammation in Alzheimer’s disease involves the activation of two types of cells in the brain: the resident immune cells called microglia, and astrocytes, star-shaped cells that support neuronal functions. In addition, there are elevated levels of cytokines, molecules that are produced by immune cells to promote inflammation. But the question remained, how does chronic inflammation in brains with Alzheimer’s disease lead to neuronal dysfunction and the consequent neurodegeneration and dementia? This study provides a major advance in the understanding of a process that leads to neuronal damage, by connecting IFN, complement and synapse loss: IFN controls the expression of multiple components of the complement cascade and mediates synapse elimination in a complement-dependent manner.

Come on in: Bile acids open the door to norovirus infection
Teams of researchers around the world have been working for more than four decades to find a way to grow this virus in the lab. Success came in 2016 from a BCM laboratory where they grew, for the first time, noroviruses in laboratory cultures of human intestinal epithelial cells. In this new study, investigators report the results of their continuing investigations to identify the bile components that are involved in promoting norovirus infection.

Making ‘sense’ of the ‘cart before the horse’
A fusion gene is a new gene made by joining parts of two different genes. It had been thought that fusion genes precede fusion RNA, but some have raised doubts that this is always the case. About 10 years ago scientists proposed the ‘cart-before-the-horse-hypothesis,’ which puts forward the idea that fusion RNA can form first and then guide the rearrangement of genes to form the corresponding fusion gene. Although this process had been found in simpler organisms, until this study, researchers had yet to come forward showing that this proposed RNA-mediate gene rearrangements also happen in mammalian cells.
E. coli shows the way to cell-made protein carcinogens
Baylor researchers discovered a new major class of cancer-promoting genes by showing that many normal proteins made by our cells can act like carcinogens, damaged DNA and causing mutations. Former graduate student and current postdoctoral associate at Baylor, Dr. Jun Xia was one of the two co-first authors on this study.

Yeast impairs memory in mice
An increasing number of clinical observations indicates that fungi are becoming a more common cause of upper airway allergic diseases such as asthma, as well as other conditions such as sepsis, a potentially life-threatening disease caused by the body’s response to an infection. Fungal infections causing airway allergic diseases and sepsis have been associated with increased risk for dementia later. This observation led Baylor researchers and colleagues to investigate the possibility that fungus might produce a brain infection and, if so, the consequences of having that kind of infection.

Sugars in mother's milk influence neonatal rotavirus infection
Rotavirus infection causes diarrhea and vomiting primarily in children younger than 5, with the exception of babies younger than 28 days of age, who usually have no symptoms. However, in some places, infections in newborns are associated with severe gastrointestinal problems. What can lead to an asymptomatic or to a clear infection is not clearly understood. BCM researchers are identifying the factors mediating differences between newborns with and without symptoms.

Team work and balance can keep a gut healthy
A significant body of work currently is indicating that the microbiota helps shape the immune system and allows it to do its job. BCM researchers are investigating the role the microbiota plays in modulating the immune response in a way that reduces the damage inflammation can do to the gut.

From the Labs
Subscribe to the From the Labs blog to keep up-to-date on all the latest research news from BCM.
Graduate School of Biomedical Sciences
The Immunology & Microbiology graduate program is part of the Baylor College of Medicine Graduate School of Biomedical Sciences. Visit the GSBS website for more information about our curriculum and admissions process as well as to find resources and services designed to support your success throughout graduate school and your future career.
Stipends and Benefits
At BCM we are focused on you and your training. If your vision for your future includes teaching, you may choose to gain experience as a teaching assistant. If you do not want to teach, you have the freedom to focus exclusively on your education and research as well as to work with your mentor to take advantage of other BCM resources that match your interests.











